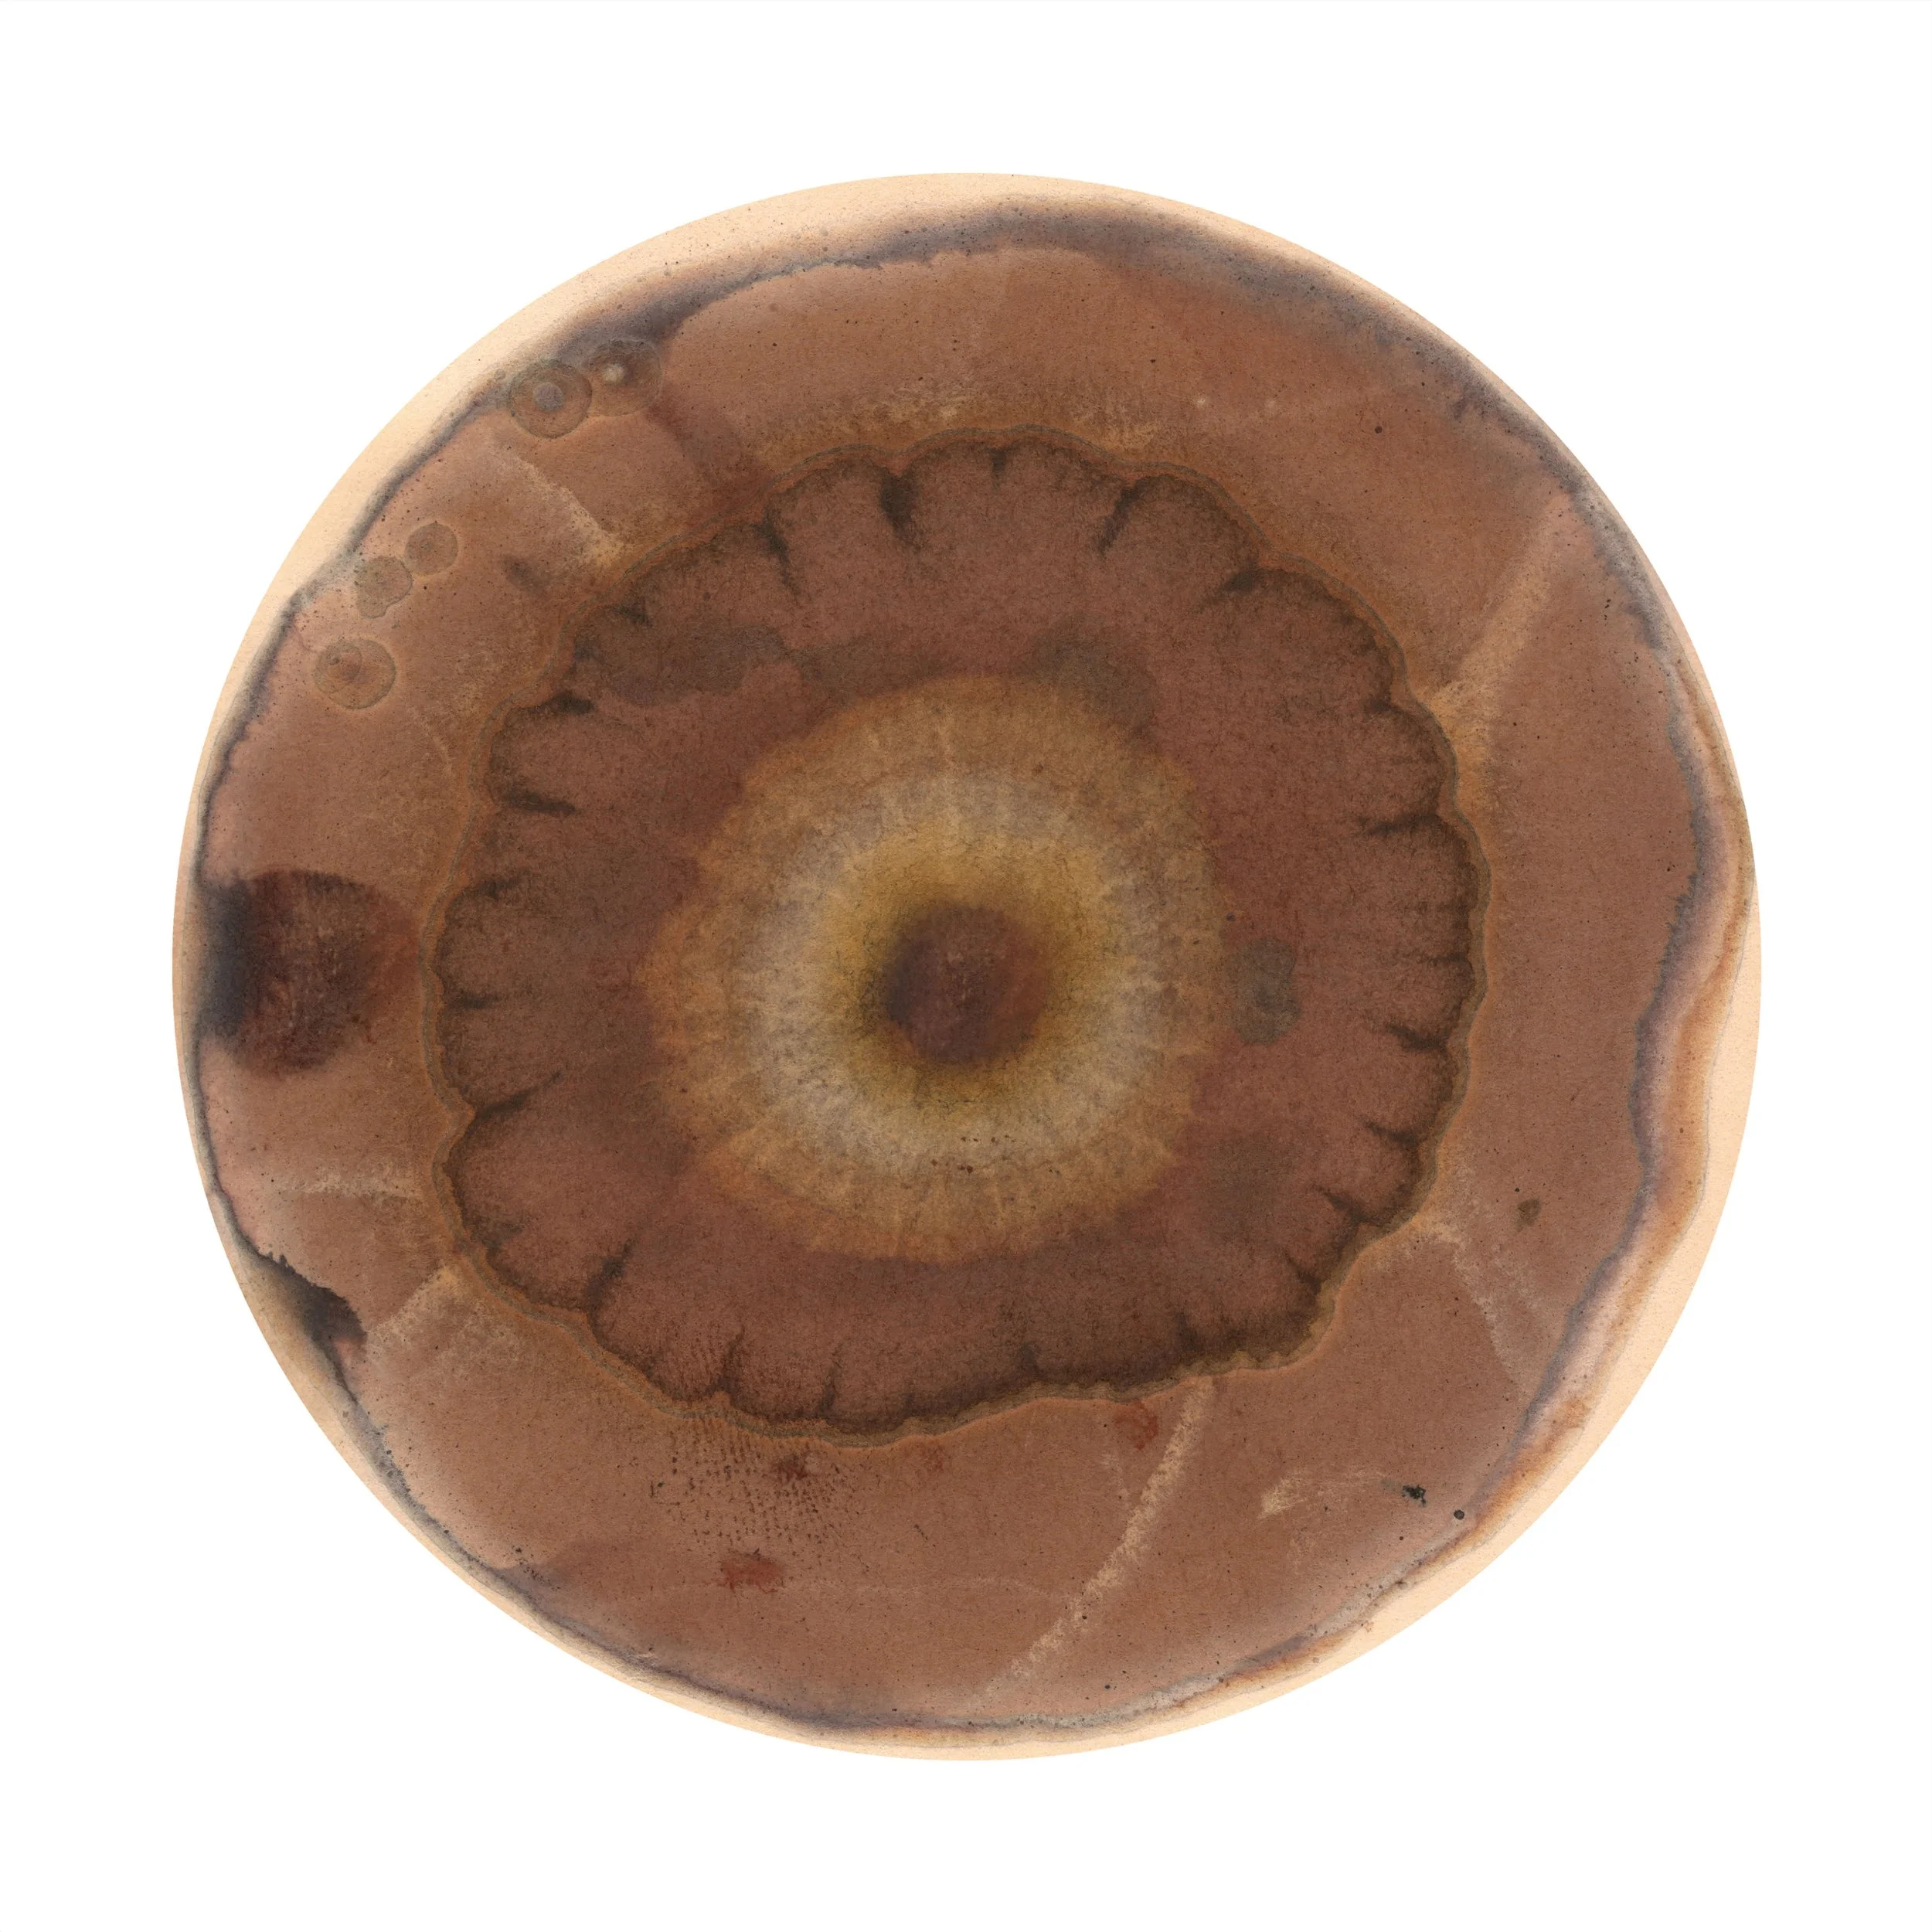

mapping country with uncle owen
photo credit: Stephanie Cobon
We are Uncle Owen Carriage and Sammy Hawker - artistic collaborators who share a cross-cultural, intergenerational friendship, formed through a shared respect and love for Country. We hope the work we make together encourages the spirit of reciprocity - and a world where we all listen and care for the voices of Country.
Uncle Owen Carriage is a Walbunja Elder of the Yuin Nation. He was born in 1953 in Milton and grew up on Walbunja Country - he is still based there, living in Kioloa. He is the founder and creator of two Indigenous newspapers, the Koori Mail and the National Indigenous Times. Uncle Owen is also a founder of the NSW South Coast Elders Council and proudly practices his culture and lore, including traditional hunting, fishing and gathering on his Country. It was Uncle Owen’s idea to incorporate Sammy’s chromatograms into his paintings.
Sammy Hawker was born in 1990 in Cootamundra (Wiradjuri Country). She is currently based in Canberra (Ngunnawal/Ngambri Country) and works as a visual artist. She has exhibited widely at public institutions across Australia and her work is held in several public collections.
Uncle Owen gave a Welcome to Country at a chromatogram workshop Sammy was hosting at Plumwood Mountain in 2023 (Walbunja Country). After the workshop, Uncle Owen had the idea for Sammy and him to collaborate together artistically. The works Uncle Owen and Sammy have been creating map walks they make together on Walbunja Country.
Together they create a series of original chromatograms co-created with significant landmarks they encounter on their walks. Chromatography is a scientific process used to understand the chemical makeup of organic matter. The hues and patterns that spread out on the paper are like a self-portrait of the materials being used to create them and the process can be thought of as facilitating the visual expression of Country. You can read more about the process of chromatography here.
Uncle Owen responds to these chromatograms through his paintings. Owen’s paintings also give voice to Country because through him Country speaks. Uncle Owen was born on Walbunja Country. It was here he learnt how to fish lobsters through feeling their horns with his feet. It was Country who hid him when the white cars pulled up to try take him and his siblings away from their family. Uncle Owen continues to actively care for his Country today as Chair of the NSW South Coast Elders Council.
A chromatogram of Uncle Owen’s glider tree, 2023
Uncle Owen Carriage & Sammy Hawker, Walking Murramarang, 2024, 63cm H x 93.5cm W, synthetic polymer paints on canvas, glue, original chromatograms (created from silver nitrate, sodium hydroxide, spotted gum, bottlebrush, soil from artefact scatter site, sand, cuttlefish bone and rainwater pooled in a grinding stone on filter paper)
Uncle Owen Carriage & Sammy Hawker, Glider Tree on Plumwood Mountain, 2023-4, synthetic polymer paints on canvas, glue, scanned chromatogram printed on archival cotton rag
A selection of chromatograms from our walks:
These are scans of the chromatograms after they are first developed. The original chromatograms are processed on 9cm filter paper with silver nitrate. These continue to process in light over time and can be thought of as living works as their colours darken and transform. These scans are similar to photographs in that they mark a moment in time of the life cycle of the chromatogram.
Chromatogram of leaves sitting in a grinding stone, 2023
Chromatogram of moss growing in a grinding stone, 2023
Chromatogram of black curly seaweed found on Depot Beach walk, 2024
Chromatogram of seaweed found on Depot Beach walk, 2024
Chromatogram of abalone shell found on Depot Beach walk, 2024
Chromatogram of bottlebrush tree #2, 2023
Chromatogram of soil from artefact scatter site, 2023
Chromatogram of cuttlefish bone found on Depot Beach walk, 2024
Chromatogram of hibbertia growing near grinding stones, 2023
Uncle Owen holding the hibbertia
Copyright © All rights reserved.